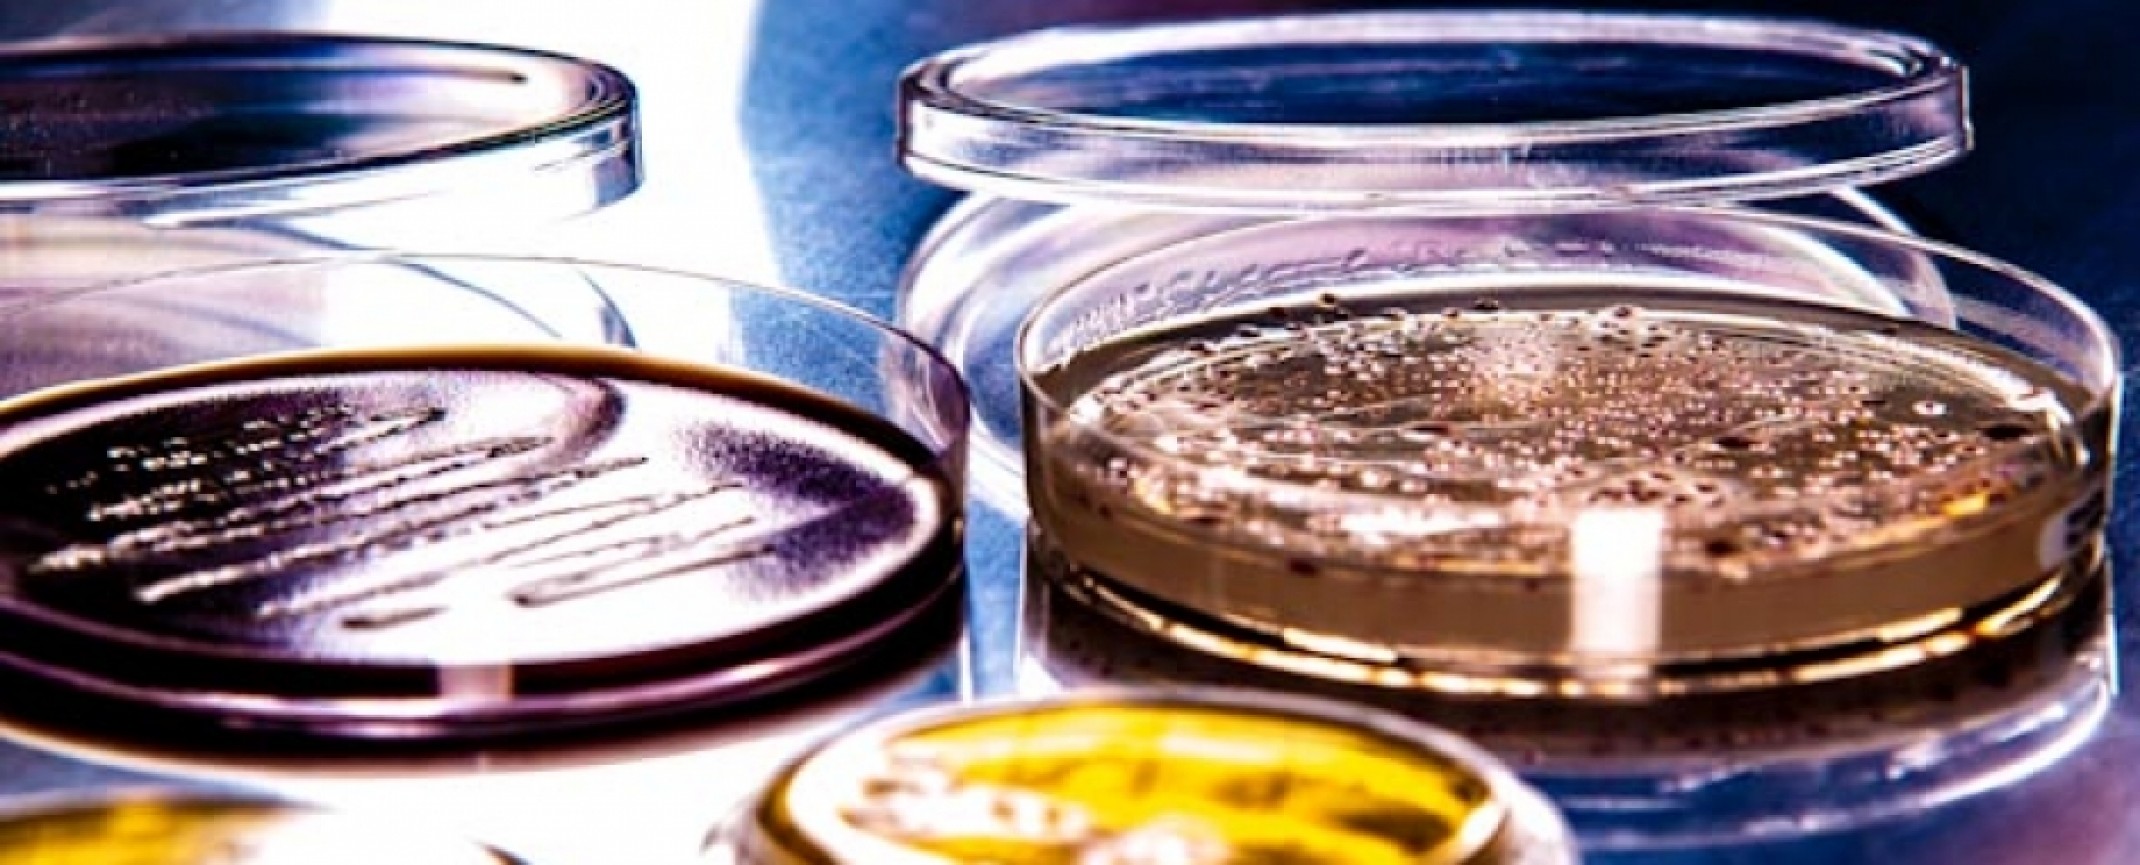
Mikrobiologia przemysłowa

Wiele branż przemysłowych zajmuje się produkcją lub dystrybucją dóbr, dla których spełnianie wymogów czystości mikrobiologicznej ma kluczowe znaczenie. Dla wieku gałęzi przemysłu bezpieczeństwo mikrobiologiczne wytwarzanych produktów jest warunkiem dopuszczenia ich na rynek.
Wykonujemy kwalifikację pomieszczeń czystych. Współpracujemy z firmą CR Konsulting w zakresie mikrobiologii.
Na życzenie klienta dojeżdżamy i pobieramy próby do badań.


Oferta Mikrografii
w zakresie mikrobiologii przemysłowej
W naszym nowoczesnym laboratorium przeprowadzamy kompleksową analizę dostarczonych nam próbek pod kątem czystości mikrobiologicznej. Korzystamy
z wysokiej jakości podłoży mikrobiologicznych oraz najnowocześniejszego sprzętu. Dbamy o to, aby wszystkie dokonywane przez nas analizy przebiegały z ogólnie przyjętymi standardami
w zakresie kontroli mikrobiologii przemysłowej.